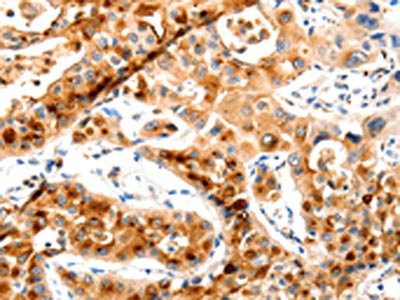

MAP2K2 Antibody
-
中文名稱:MAP2K2兔多克隆抗體
-
貨號:CSB-PA224661
-
規格:¥1100
-
圖片:
-
The image on the left is immunohistochemistry of paraffin-embedded Human lung cancer tissue using CSB-PA224661(MAP2K2 Antibody) at dilution 1/20, on the right is treated with synthetic peptide. (Original magnification: ×200)
-
The image on the left is immunohistochemistry of paraffin-embedded Human ovarian cancer tissue using CSB-PA224661(MAP2K2 Antibody) at dilution 1/20, on the right is treated with synthetic peptide. (Original magnification: ×200)
-
Gel: 10%SDS-PAGE, Lysate: 40 μg, Lane 1-2: 293T cells, NIH/3T3 cells, Primary antibody: CSB-PA224661(MAP2K2 Antibody) at dilution 1/400, Secondary antibody: Goat anti rabbit IgG at 1/8000 dilution, Exposure time: 10 seconds
-
-
其他:
產品詳情
-
Uniprot No.:
-
基因名:
-
別名:Cardiofaciocutaneous syndrome antibody; CFC syndrome antibody; CFC4 antibody; Dual specificity mitogen activated protein kinase kinase 2 antibody; Dual specificity mitogen-activated protein kinase kinase 2 antibody; ERK activator kinase 2 antibody; FLJ26075 antibody; MAP kinase kinase 2 antibody; map2k2 antibody; MAPK / ERK kinase 2 antibody; MAPK/ERK kinase 2 antibody; MAPKK 2 antibody; MAPKK2 antibody; MEK 2 antibody; MEK2 antibody; Microtubule associated protein kinase kinase 2 antibody; Mitogen activated protein kinase kinase 2 antibody; Mitogen activated protein kinase kinase 2 p45 antibody; MKK 2 antibody; MKK2 antibody; MP2K2_HUMAN antibody; OTTHUMP00000165826 antibody; OTTHUMP00000165827 antibody; PRKMK 2 antibody; PRKMK2 antibody
-
宿主:Rabbit
-
反應種屬:Human,Mouse,Rat
-
免疫原:Synthetic peptide of Human MAP2K2
-
免疫原種屬:Homo sapiens (Human)
-
標記方式:Non-conjugated
-
抗體亞型:IgG
-
純化方式:Antigen affinity purification
-
濃度:It differs from different batches. Please contact us to confirm it.
-
保存緩沖液:-20°C, pH7.4 PBS, 0.05% NaN3, 40% Glycerol
-
產品提供形式:Liquid
-
應用范圍:ELISA,WB,IHC
-
推薦稀釋比:
Application Recommended Dilution ELISA 1:1000-1:5000 WB 1:200-1:1000 IHC 1:25-1:100 -
Protocols:
-
儲存條件:Upon receipt, store at -20°C or -80°C. Avoid repeated freeze.
-
貨期:Basically, we can dispatch the products out in 1-3 working days after receiving your orders. Delivery time maybe differs from different purchasing way or location, please kindly consult your local distributors for specific delivery time.
-
用途:For Research Use Only. Not for use in diagnostic or therapeutic procedures.
相關產品
靶點詳情
-
功能:Catalyzes the concomitant phosphorylation of a threonine and a tyrosine residue in a Thr-Glu-Tyr sequence located in MAP kinases. Activates the ERK1 and ERK2 MAP kinases. Activates BRAF in a KSR1 or KSR2-dependent manner; by binding to KSR1 or KSR2 releases the inhibitory intramolecular interaction between KSR1 or KSR2 protein kinase and N-terminal domains which promotes KSR1 or KSR2-BRAF dimerization and BRAF activation.
-
基因功能參考文獻:
- Data show that SAM and SH3 domain containing 1 protein (SASH1) binds with mitogen-activated protein kinase kinase 2 (MAP2K2), and SASH1 mutations promote binding between SASH1 and MAP2K2. PMID: 28382689
- findings demonstrate the interaction of tRNA with MEK2 in pancreatic cancer cells and suggest that tRNA may impact MEK2 activity in cancer cells PMID: 27301426
- MEK2 was essential for the phosphorylation of MKK3/MKK6 and p38 MAPK that directly impacted on cyclin D1 expression. PMID: 27181679
- High MEK2 expression is associated with inflammation. PMID: 28178421
- there were significant decreases in intercellular adhesion molecules 1 (ICAM1), ezrin (EZR), mitogen-activated protein kinase kinase 2 (MAP2K2), and nitric oxide synthase 3 (NOS3) gene expressions in metabolic syndrome patients. PMID: 26956845
- The patient showed a paternally inherited 16p13.11 microduplication and a de novo 19p13.3 microdeletion involving the mitogen-activated protein kinase kinase 2 gene (MAP2K2), in which mutations cause the cardio-facio-cutaneous (CFC) syndrome PMID: 27751966
- We report on a fourth familial case with transmission of CFC syndrome from father to son due to a novel heterozygous sequence change c.376A>G (p.N126D) in exon 3 of MEK2 gene. PMID: 25487361
- MK2 attenuates dendritic cell-mediated Th1 differentiation and autoimmune encephalomyelitis. PMID: 26078274
- Our cohort of seven individuals with MEK2 deletions has overlapping features associated with RASopathies. PMID: 23379592
- Both ACE inhibition and MEK1/2 inhibition have beneficial effects on left ventricular function in Lmna(H222P/H222P) mice and both drugs together have a synergistic benefit when initiated after the onset of left ventricular dysfunction. PMID: 25218145
- we report familial patients with multiple cafe au lait spots and Noonan syndrome-like facial features who carried mutations in MAP2K2. PMID: 24311457
- osteosarcoma patients whose tumors expressed pMEK2 had a poorer clinical outcome than those whose tumors did not. PMID: 22935974
- MEK2 regulates ribonucleotide reductase activity through functional interaction with ribonucleotide reductase small subunit p53R2. PMID: 22895183
- E-cadherin is necessary for localization of DLG1 but not phosphorylated MEK2 to the midbody ring during cytokinesis. PMID: 22185284
- Mycobacterium tuberculosis lipomannan blocks TNF biosynthesis by regulating macrophage MAPK-activated protein kinase 2 (MK2) and microRNA miR-125b. PMID: 21969554
- hDlg acts as a MEK2-specific scaffold protein for the ERK signaling pathway. PMID: 21615688
- Data report the full-length structure of MEK2 obtained by homology modeling and molecular dynamics simulations. PMID: 21509657
- In the absence of other MKK, MEK2 is sufficient for SK-MEL-28 cell proliferation and anchorage-dependent growth. PMID: 21365009
- ETS1 is probably mediating high CIP2A expression in human cancers with increased EGFR-MEK1/2-ERK pathway activity PMID: 21445343
- familial inheritance of cardiofaciocutaneous syndrome with MEK2 mutation PMID: 21178588
- MEK1 and MEK2 play a part in the induction of the proinflammatory cytokine. PMID: 20837746
- This first reported case of a vertically transmitted functional Cardio-facio-cutaneous syndrome MEK mutation. PMID: 20358587
- MEK2 activity ad dual-phosphorylation were undetectable in expanding and self-renewing hematopoietic progenitors (HP). Adding IL-3, inducing maturation and cell death in HP, led to sustained high levels of MEK2 activity and dual-phosphorylation. PMID: 12032872
- MK2 phosphorylates TSC2, which creates a 14-3-3 binding site and thus regulates the cellular function of the TSC2 tumor suppressor protein PMID: 12582162
- MAPK activated protein kinase-2 mediates both ERK- and p38 MAPK-dependent neutrophil responses. PMID: 14499342
- HuR and MK2 in regulating the expression of uPA and uPAR genes at the posttranscriptional level PMID: 14517288
- Results suggest a physiological link between beta-dystroglycan and mitogen-activated protein kinase kinase 2 (MEK2), and localize MEK with dystroglycan in membrane ruffles. PMID: 15071496
- The ability of constitutively-active human MEK2 to stimulate ERK phosphorylation and to induce the neoplastic transformation of NIH 3T3 cells required the integrity of the D-site was found. PMID: 15979847
- These data suggest a role for mitochondrially generated reactive oxygen species and Ca(2+) in the redox cell signaling path-ways, leading to ERK activation and adaptation of the pathological stress mediated by oxidized lipids such as lysoPC. PMID: 16651638
- 3 novel mutations for MEK2 (L46_E55del, K61T, A62P) were identified in 15 patients with cardio-facio-cutaneous syndrome. PMID: 17704260
- Spectrum of MEK2 gene mutations in cardio-facio-cutaneous syndrome and genotype-phenotype correlations PMID: 19156172
- MEK2 interacts with ERK1. This interaction is mediated via a conserved N-terminal docking site in MEK2. PMID: 11134045
顯示更多
收起更多
-
相關疾病:Cardiofaciocutaneous syndrome 4 (CFC4)
-
亞細胞定位:Cytoplasm. Membrane; Peripheral membrane protein.
-
蛋白家族:Protein kinase superfamily, STE Ser/Thr protein kinase family, MAP kinase kinase subfamily
-
數據庫鏈接:
Most popular with customers
-
-
YWHAB Recombinant Monoclonal Antibody
Applications: ELISA, WB, IHC, IF, FC
Species Reactivity: Human, Mouse, Rat
-
Phospho-YAP1 (S127) Recombinant Monoclonal Antibody
Applications: ELISA, WB, IHC
Species Reactivity: Human
-
-
-
-
-